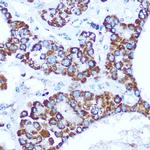
Caspase 1 Antibody in Immunohistochemistry (Paraffin) (IHC (P))

Search
Invitrogen
Caspase 1 Polyclonal Antibody
{{$productOrderCtrl.translations['antibody.pdp.commerceCard.promotion.promotions']}}
{{$productOrderCtrl.translations['antibody.pdp.commerceCard.promotion.viewpromo']}}
{{$productOrderCtrl.translations['antibody.pdp.commerceCard.promotion.promocode']}}: {{promo.promoCode}} {{promo.promoTitle}} {{promo.promoDescription}}. {{$productOrderCtrl.translations['antibody.pdp.commerceCard.promotion.learnmore']}}
产品信息
PA5-120654
宿主/亚型
分类
类型
抗原
偶联物
形式
浓度
保存条件
运输条件
RRID
产品详细信息
Positive test controls include: HeLa, THP-1, Mouse lung. The target is usually found in the following locations: Cytoplasm.
靶标信息
Caspases are a family of cysteine proteases that can be divided into the apoptotic and inflammatory caspase subfamilies. Unlike the apoptotic caspases, members of the inflammatory subfamily are generally not involved in cell death but are associated with the immune response to microbial pathogens. Members of this subfamily include caspase-1, -4, -5, and -12 and can activate proinflammatory cytokines such as IL-1-b and IL-18. Caspase-1 was initially identified as an IL-1-b-converting enzyme; later experiments revealed it to be a mammalian homolog of the C. elegans cell death gene ced-3 whose overexpression can induce apoptosis in fibroblasts.
仅用于科研。不用于诊断过程。未经明确授权不得转售。